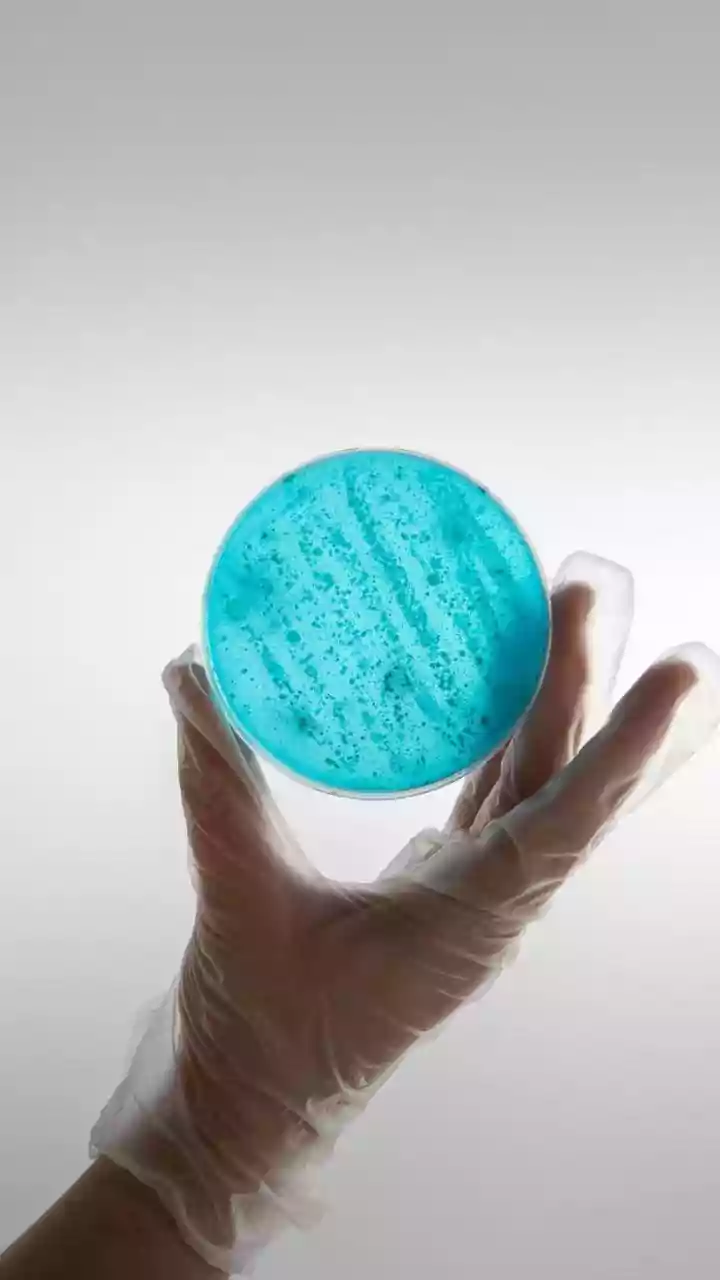
Gonorrhea Treatment Advances: New Antibiotics Approved

Smartwatch Revolution
Smartwatches have evolved into multi-functional devices, moving beyond simple timekeeping. These sophisticated gadgets now track a variety of metrics,
including heart rate, sleep patterns, and activity levels. Many models offer GPS for navigation, allowing users to monitor their routes during workouts or outdoor activities. Some smartwatches even facilitate phone calls and notifications, enhancing connectivity and streamlining daily tasks. The integration of apps, such as those for health and communication, further enhances the capabilities of these devices, making them indispensable for many users.
Beyond Wrist Wear
While smartwatches dominate the wearable market, other devices are gaining popularity. Smart bands, for instance, offer similar fitness tracking functionalities in a more compact and affordable form factor. These bands typically focus on basic health metrics, such as step counts and sleep analysis. Beyond wrist-worn devices, other wearables include smart rings, which monitor health data and provide notifications. Smart glasses are another area of growth, offering hands-free access to information and augmented reality experiences. This diverse range of devices showcases the evolving nature of wearable tech, with innovations constantly emerging to meet different user needs.
Fitness Tracking
Fitness tracking is a core feature of many wearables. These devices employ sensors to monitor physical activity, allowing users to track their progress and achieve their health goals. Smartwatches and bands can record steps taken, distance traveled, and calories burned. More advanced models measure heart rate variability (HRV), offering insights into stress levels and overall health. Wearable technology also facilitates detailed workout tracking, helping users analyze their performance during various exercises. This data-driven approach empowers individuals to make informed decisions about their fitness routines, promoting a healthier lifestyle. The ability to set goals and monitor progress provides the motivation needed to achieve desired results.
Health Monitoring
Beyond fitness tracking, wearables are used for health monitoring. Many devices include features that track sleep quality, offering insights into sleep stages and duration. Some wearables can also detect irregularities in heart rhythms, such as atrial fibrillation, alerting users to potential health concerns. The integration of sensors capable of monitoring blood oxygen saturation and other vital signs allows for comprehensive health assessments. The data collected by these devices can be shared with healthcare professionals, improving patient care and potentially enabling early detection of health issues. This capability underscores the potential of wearables to transform healthcare, offering users the tools needed to take proactive steps towards better health.
Connectivity and Apps
Wearable devices seamlessly integrate with smartphones, enabling a range of connectivity features. Users can receive notifications for calls, messages, and emails directly on their wrists, eliminating the need to constantly check their phones. Smartwatches often support mobile payments, allowing users to make purchases with a simple tap. The availability of apps significantly enhances the functionality of wearables. Users can access apps for fitness, navigation, music, and communication. The ability to download apps extends the capabilities of wearables, making them customizable to individual needs. This ecosystem of apps fosters a personalized experience, catering to a diverse set of users. These integrations promote better connectivity and streamline digital interactions.
The Future Outlook
The future of wearables is promising, with continuous advancements driving innovation. One trend is the miniaturization of devices, leading to smaller, more discreet form factors. The integration of advanced sensors will enable more precise health monitoring, with the potential to detect and prevent diseases. The development of advanced materials will enhance comfort and durability, making wearables even more appealing to users. Augmented reality (AR) and virtual reality (VR) technologies will likely play a more significant role, creating immersive experiences. The evolution of wearable technology is set to transform various sectors, including healthcare, fitness, and communication, making these gadgets an increasingly integral part of daily life.